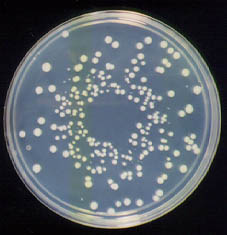

Изучение микробной ДНК, выделенной из содержимого человеческого кишечника, позволило американским ученым показать высокое видовое разнообразие кишечной флоры и ее важную роль в обмене веществ. По мнению исследователей, человек вместе с живущими в его кишечнике микробами представляет собой единый «сверхорганизм». Обмен веществ этого сверхорганизма в значительной степени определяется ферментами, гены которых локализованы не в человеческих хромосомах, а в геномах симбиотических микробов.
В молекулярно-биологических исследованиях главный залог успеха — это удачный выбор объекта и методики. Новые эффективные методы, разработанные для решения конкретных задач, могут вдруг оказаться весьма полезными и в совершенно других областях. Именно это и произошло в данном случае.
Большая группа биологов из шести научно-исследовательских учреждений США нашла необычное применение новейшим методикам, разработанным для «прочтения» геномов различных организмов. Ученые применили эти методы к ДНК, экстрагированной из человеческих фекалий, с целью получения общей характеристики кишечной микрофлоры.
По имеющимся оценкам, в кишечнике взрослого человека присутствует более 1 кг микроорганизмов, относящихся к сотням различных видов. В точности их видовой состав неизвестен. Микробиологи знают «в лицо» лишь несколько десятков типичных представителей, которых можно вырастить на искусственных средах. Как выяснилось сравнительно недавно (и это открытие стало шоком для микробиологов), большинство существующих в природе микроорганизмов на искусственных средах не растет. Таких микробов называют «некультивируемыми». В человеческом кишечнике они тоже, скорее всего, составляют большинство. Что-либо узнать об этих микробах удается лишь по нуклеотидным последовательностям ДНК в пробах, взятых из естественных сред.
Исследователи выделили ДНК из фекалий двух человек, не принимавших целый год перед этим никаких лекарств, и провели масштабную работу по секвенированию — определению нуклеотидной последовательности фрагментов ДНК. Отсеквенированные кусочки затем собирались в более длинные фрагменты на основе наличия перекрывающихся концевых участков. В итоге получилось около 74 тысяч неповторяющихся кусков общей длиной свыше 78 миллионов пар оснований. Для сравнения, в геноме человека 2,85 миллиарда пар оснований, в геноме одной бактерии обычно 2–5 миллионов пар оснований.
Понятно, что авторы исследования не рассчитывали получить полные геномы всех кишечных микробов. Для этого им пришлось бы приложить на несколько порядков больше усилий. На данном этапе они лишь хотели получить общее представление о разнообразии микробного сообщества, его структуре и, главное, обмене веществ. А для этого полученной выборки геномных последовательностей оказалось вполне достаточно.
Такой радикальный подход к изучению сообществ — свалить всех в одну кучу, истолочь и отсеквенировать — получил даже специальное название: «метагеномный анализ».
На следующем этапе в отсеквенированных последовательностях искали гены с известными функциями и пытались определить, какие фрагменты принадлежат бактериям, а какие археям. Для этого последовательности сравнивались с известными, то есть внесенными в базы данных генами бактерий и архей, а также с их полными геномами. Отдельно анализировались гены рибосомной РНК (16S), по которым традиционно проводят классификацию микробов.
В «явном виде» по генам рибосомной РНК удалось идентифицировать лишь 72 разновидности бактерий (из них 60 некультивируемых и 16 новых для науки) и один вид архей (метаноген Methanobrevibacter smithii), однако авторы обосновали статистически, что, если бы работа по секвенированию ДНК из тех же самых проб была продолжена, число выявленных разновидностей микробов составило бы не менее 300. Авторы относили к различным «разновидностям» те гены рибосомной РНК, у которых сходство нуклеотидных последовательностей не превышало 97%.
Исследователи проанализировали количественное распределение выявленных микробных генов по функциональным группам с целью реконструкции основных особенностей «совокупного метаболизма» кишечной флоры. Для этого процентное соотношение генов с разными функциями во всех прочтенных микробных геномах сравнивалось с тем, которое обнаружилось в изучаемой выборке.
Оказалось, что в кишечной микрофлоре резко повышена доля генов, имеющих отношение к метаболизму полисахаридов растительного происхождения, некоторых аминокислот и витаминов, а также к метаногенезу. На основе проведенного анализа авторы выделили наиболее важные метаболические функции, которые выполняют микробы в человеческом кишечнике. Это, прежде всего, переваривание растительных полисахаридов, которые не могут перевариваться ферментами, закодированными в геноме человека. С этими трудноусваиваемыми углеводами расправляются в основном бактерии-бродильщики, выделяющие в качестве конечных продуктов обмена низкомолекулярные органические кислоты (ацетат, пропионат, бутират). Однако то, что для бактерий-бродильщиков является отходами жизнедеятельности, для человека — вполне «съедобные» вещества, которые активно всасываются кишечным эпителием. По имеющимся оценкам, из этого необычного источника люди получают около 10% калорий (эта оценка справедлива для приверженцев типичной «европейской» диеты).
Кроме съедобных для человека веществ бактерии-бродильщики выделяют в качестве побочного продукта еще и молекулярный водород (H2), который вреден для них самих и препятствует их росту и жизнедеятельности. Чтобы процесс переваривания растительных полисахаридов шел эффективно, кто-то должен постоянно утилизировать образующийся водород. Именно этим и занимается метаноген Methanobrevibacter smithii и, возможно, некоторые другие археи-метаногены и бактерии-сульфатредукторы. В ходе метаногенеза поглощается водород и углекислый газ и выделяется метан.
В «совокупном геноме» кишечной флоры сильно повышено процентное содержание генов, связанных с синтезом незаменимых аминокислот и витаминов. Микробы сильно облегчают человеку жизнь, производя значительные количества этих необходимых нам веществ. Кроме того, кишечная флора располагает большим арсеналом ферментов для обезвреживания токсичных веществ, присутствующих в нашей повседневной пище, особенно растительной.
Микробные геномы, таким образом, служат важным дополнением геному Homo sapiens. Хоть это и нехарактерно для публикуемых в наши дни на Западе научных работ, авторы в данном случае решились на философское обобщение. По их мнению, человека следует рассматривать как «сверхорганизм», чей обмен веществ обеспечивается совместной слаженной работой ферментов, закодированных не только в геноме Homo sapiens, но и в геномах сотен видов симбиотических микробов. Между прочим, доля человеческих генов в совокупном геноме этого «сверхорганизма» составляет не более 1%.
Источник: Steven R. Gill et al. Metagenomic Analysis of the Human Distal Gut Microbiome // Science. 2006. V. 312. P. 1355–1359.
См. также:
Переносчиком растительных инфекций может быть человек, «Элементы», 22.12.2005.



